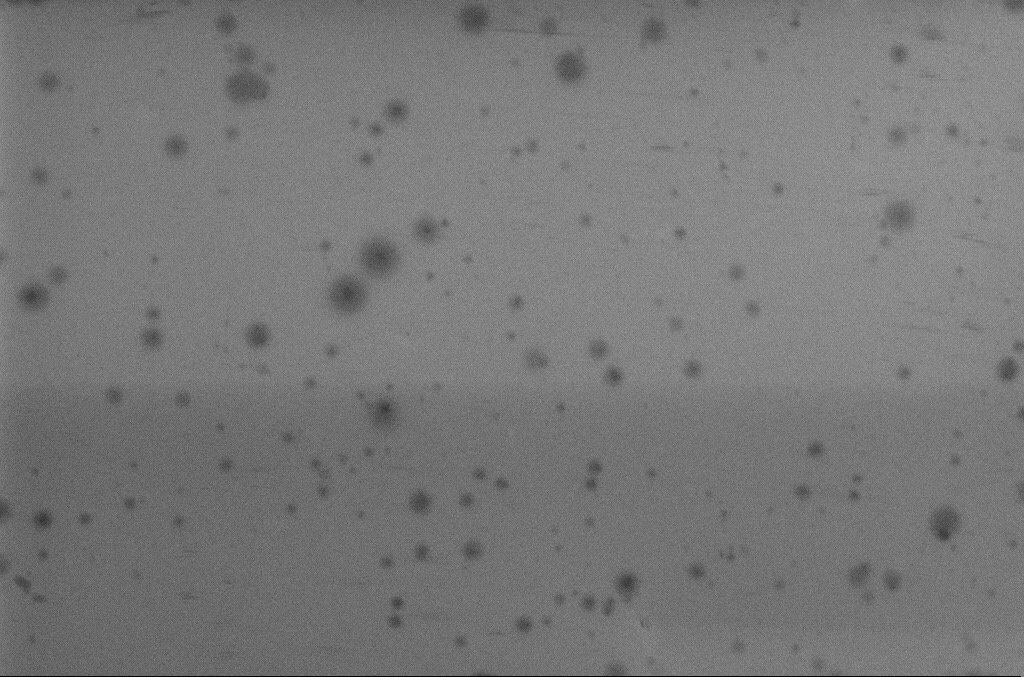

staging
過去進入液態樣品檢測的微觀世界有兩大難題:
而邑流微測的液態樣品檢測技術,解決了這兩個難題。透過獨家液態樣品檢測系統讓液態樣品在SEM底下仍可以維持原始狀態。
再搭配高階影像分析系統,快速產出實驗數據,如粒徑分析、分散/團聚、濃度、形狀、成分組成...等數值。不論是新材料研發或是學術研究都能獲得不錯的成果。
話不多說,快來看看優酪乳在SEM底下的樣子!
|
| ▲SEM底下的果膠分子原貌 |
優酪乳,又稱為酸奶或發酵乳,主要由牛奶和乳酸菌發酵而成。不過,除了生乳、糖、水和乳酸菌,優酪乳到底還加了甚麼?
果膠一種天然的高分子化合物,是植物細胞壁的成分之一,使植物細胞能緊密相黏;通常可由水果的皮萃取出來,具有很好的膠凝化、乳化穩定作用,現金已被食品、醫藥、紡織等產業廣泛應用。對人體而言,果膠是一種無法消化的水溶性纖維;但對優酪乳來說,果膠扮演著「穩定劑」的角色,避免乳製品中的蛋白質聚集沉澱或乳清分離。果膠含有的酯官能基,會使果膠分子間產生鍵結,增加優酪乳的濃稠度;同時,果膠也會和水形成鍵結,提升優酪乳的順口度。這也是SEM分析最大的目的,因微觀世界中的分子結構往往是決定原物料特性的關鍵。從上圖影像中,我們清楚可見SEM分析的果膠分子尺寸大小、分布狀況,再搭配專門的影像分析軟體,進行自動化數據分析,此SEM分析資料將是食品工業產品研發、配方改善的重要依據。最重要的是,不同於過去液態的樣品檢測會因為SEM必須抽真空而導致SEM分析的數據偏離真實,邑流微測新型的液態材料檢測系統可以提供目前業界最完整的結果報告。
優酪乳主要是由牛奶與乳酸菌發酵而成,所以牛奶含有的豐富營養成分,如蛋白質、鈣質、維生素B群與礦物質等,優酪乳也通通具備。不過相比之下,優酪乳更好消化與吸收,使它的營養素利用率有所提高。
維持消化道機能、提高免疫力
優酪乳含有的益生菌,可以幫助改善腸道菌相,讓好菌多過於壞菌。乳酸菌可以藉由發酵作用,讓牛奶原本含有的維生素B群更加豐富、營養成分變成小分子,使人體更容易吸收,也較不容易發生脹氣現象。除此之外,乳酸菌也能藉由活化巨噬細胞,增強人體的免疫力,刺激人體免疫系統產生抗體,抑制腫瘤的形成。
降低結腸癌發生機率
優酪乳透過乳酸菌的作用,能夠降低糞便內致癌酵素的濃度,減少致癌物的產生與罹癌的機會。此外,腸道乳酸菌代謝所產生的丁酸,也有抑制腸道內腫瘤增生與分化的功效。
Q:你以為的「原味」優酪乳,就是無添加物、無色素或無調味?不含防腐劑的優酪乳,比較健康?
A:其實,市面上有許多看似是白色的優酪乳,都符合CNS3058標準,實屬「調味發酵乳」,而不是真正的原味優酪乳。因此,大家在選購時,還是要以成分說明為準唷!此外,優酪乳產品在製程中本來就禁止摻用防腐劑,所以市售優酪乳產品包裝上的「不含防腐劑」,只是行銷手法罷了,千萬別傻傻被騙!
Q:我喝牛奶會腹瀉,是不是優酪乳也不能喝?
A:牛奶中的「乳糖」,是導致喝牛奶腹瀉的罪魁禍首。在優酪乳的發酵過程中,不僅乳糖會變成乳酸與其他有機酸,乳酸菌本身也會產生大量的「乳糖酶」,來幫助人體分解乳糖。因此,一般患有乳糖不耐症的患者,可以考慮改喝優酪乳,來攝取相似的營養成分唷!
Q:嬰幼兒可以喝優酪乳嗎?
A:1歲以下的嬰幼兒,處於發育階段,腸胃系統的功能較弱,微生物菌群也處於變化階段,較不穩定;此時若飲用冰冷的優酪乳,將有機會引起腸道的菌種平衡失調,影響消化吸收,甚至引發腸道疾病。因此,較不建議飲用優酪乳。
1歲以上的嬰幼兒,因腸胃系統發育較完全,比較不會對牛奶蛋白過敏,所以是可以適量飲用優酪乳的;建議選擇鈣質含量高且低糖分的品項,並以每日400cc以下為基準進行攝取。
更多液態材料檢測的應用: